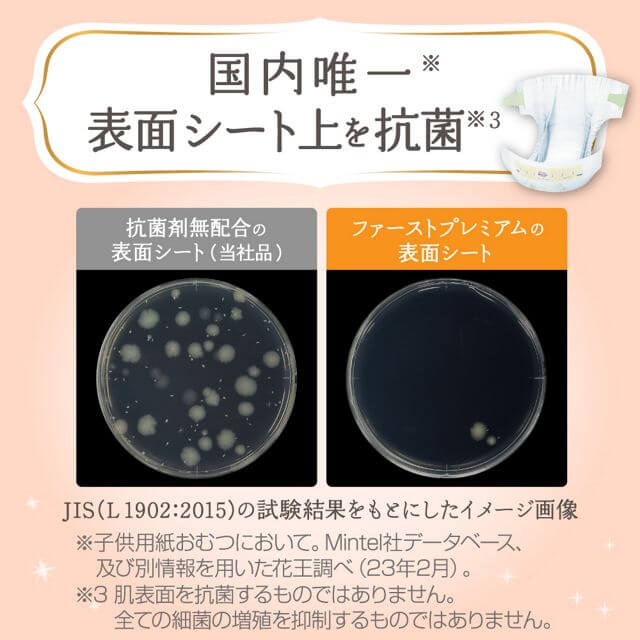

KAO Merries - First Premium - Small Nappy Tape for 4-8Kg - Size S - 60 Pieces
Tax included
Shipping calculated at checkout
Pickup currently unavailable
-
Small (S) , Size 2
-
Suitable For: 4-8 kg
-
[Jumbo Value Pack] 60 Nappies, Tape per Bag
-
Directly Imported from Japan
-
Local stock in Melbourne, Australia
-
Same Day Dispatch
-
Delivery by Australia Post with Tracking and Signature
-
Note: As Japanese product packaging is often limited/revisioned, if the photo is too late to be replaced, please refer to the actual product received.
Made by KAO Merries in Japan for exceptional quality
Cashmere Touch: A luxurious texture that keeps you wanting more
Fluffy Air-In Cushion: Soft and gentle against the skin, designed for newborns and effective poop absorption
100% Breathable Material: Keeps your baby's skin dry and free from stuffiness
Argan Oil Infused: Organic and high-purity argan oil for a soothing touch on baby’s skin
Safe and Long-Lasting Absorption: Reliable absorption even on lush mornings
Born in skin research, we use carefully selected high-quality materials for the first time on the skin.
Twice as soft: Achieve a high-quality feel that delicately wraps your baby’s skin with a cashmere touch.
Active waistband for flexible and comfortable movement.
Ensures baby comfort and peace of mind against leakage.
The unique fluffy air cushion provides soft and comfortable contact with the skin.
100% breathable material prevents stuffiness throughout the entire diaper, keeping your skin silky.
Please note that this is a Japanese product with labels written only in Japanese.
Machine translation used above may include obscure expressions.
Actual product packaging may differ from the image shown.
Made in Japan.